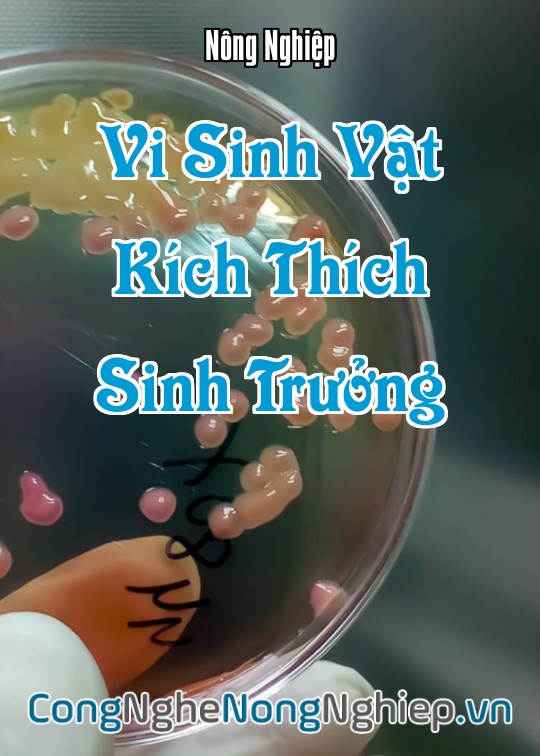
Ảnh bìa sách Vi Sinh Vật Kích Thích Sinh Trưởng

VI SINH VẬT KÍCH THÍCH SINH TRƯỞNG
Người đăng : Nông Nghiệp
Lượt xem : 434
Tạo lúc : Wed, 02/07/2025 17:53
Cập nhật lúc : 17:53pm 02/07/2025
Vi Sinh Vật Kích Thích Sinh Trưởng: Bí Quyết Khoa Học Nâng Tầm Năng Suất Và Sức Khỏe Cây Trồng Bền Vững
Trong nền nông nghiệp hiện đại, việc tối ưu hóa sự phát triển của cây trồng không chỉ dừng lại ở việc cung cấp dinh dưỡng. Vi sinh vật kích thích sinh trưởng (Plant Growth-Promoting Microorganisms - PGPMs) là những "người bạn" thầm lặng, đóng vai trò quan trọng trong việc thúc đẩy cây lớn nhanh, khỏe mạnh và đạt năng suất cao thông qua nhiều cơ chế sinh học độc đáo. Hiểu rõ về vi sinh vật kích thích sinh trưởng, tầm quan trọng, cơ chế hoạt động và biện pháp ứng dụng khoa học là chìa khóa để kiến tạo một nền nông nghiệp thịnh vượng, hiệu quả và thân thiện với môi trường. Bài viết này từ congnghenongnghiep.vn sẽ trình bày một cách khoa học về vi sinh vật kích thích sinh trưởng trong nông nghiệp.
1. Giới Thiệu Chung Về Vi Sinh Vật Kích Thích Sinh Trưởng
Đất là yếu tố quan trọng trong nông nghiệp. Đất được định nghĩa là hỗn hợp của chất vô cơ, mùn, nước và không khí. Đất tốt thực hiện tốt ba chức năng chính trong nông nghiệp, trong đó có việc giữ gìn và cung cấp chất dinh dưỡng.
Vi sinh vật kích thích sinh trưởng (PGPMs) là một nhóm đa dạng các vi sinh vật sống trong đất hoặc có mối liên hệ với cây trồng (trên rễ, lá, thân), có khả năng trực tiếp hoặc gián tiếp thúc đẩy sự phát triển của cây. Chúng bao gồm nhiều chủng vi khuẩn (ví dụ: Azotobacter, Azospirillum, Bacillus, Pseudomonas, Rhizobium) và nấm (ví dụ: Mycorrhizae, một số chủng Trichoderma).
2. Các Loại Vi Sinh Vật Kích Thích Sinh Trưởng Phổ Biến
Các nhóm PGPMs được ứng dụng rộng rãi và mang lại hiệu quả cao bao gồm:
-
Vi khuẩn cố định đạm:
-
Cộng sinh: Rhizobium (trên cây họ đậu) - giúp chuyển đạm khí quyển thành dạng cây sử dụng được.
-
Tự do: Azotobacter, Azospirillum (thường liên kết với rễ cây hòa thảo như lúa, ngô) - cố định đạm từ không khí.
-
-
Vi khuẩn phân giải lân/kali: Các chủng Bacillus, Pseudomonas có khả năng hòa tan các hợp chất lân và kali khó tan trong đất thành dạng dễ hấp thụ cho cây.
-
Nấm rễ cộng sinh (Mycorrhizae): Hình thành mối quan hệ cộng sinh với rễ cây, mở rộng đáng kể diện tích hấp thụ nước và dinh dưỡng (đặc biệt là lân).
-
Vi khuẩn sản xuất hormone thực vật: Nhiều chủng Bacillus, Azotobacter, Azospirillum, Pseudomonas có khả năng tổng hợp các chất điều hòa sinh trưởng thực vật tự nhiên.
-
Vi khuẩn/nấm đối kháng: Giúp kiểm soát mầm bệnh, từ đó gián tiếp giúp cây sinh trưởng tốt hơn (Trichoderma, Bacillus).
-
Vi khuẩn axit lactic (LAB): Giúp cải thiện môi trường đất, thúc đẩy phân giải hữu cơ.
-
Men (Yeast): Có khả năng sản xuất vitamin và axit amin.
3. Cơ Chế Kích Thích Sinh Trưởng Của Vi Sinh Vật
PGPMs thúc đẩy sự phát triển của cây trồng thông qua các cơ chế chính:
3.1. Cơ Chế Trực Tiếp (Cung Cấp/Tối Ưu Hóa Dinh Dưỡng)
-
Cố định đạm: Cung cấp nguồn đạm tự nhiên từ khí quyển, giảm nhu cầu phân đạm hóa học.
-
Hòa tan khoáng chất: "Mở khóa" các nguyên tố dinh dưỡng như lân, kali, sắt, kẽm từ các hợp chất khó tan trong đất thành dạng cây dễ hấp thụ.
-
Sản xuất hormone thực vật (Phytohormones):
-
Auxin: Kích thích sự phát triển và kéo dài của rễ, tăng số lượng lông hút, từ đó mở rộng diện tích hấp thụ nước và dinh dưỡng của cây.
-
Gibberellin: Thúc đẩy sự tăng trưởng chiều cao thân, kéo dài lóng, kích thích ra hoa.
-
Cytokinin: Kích thích phân chia tế bào, phát triển chồi bên, làm chậm quá trình lão hóa lá.
-
-
Sản xuất vitamin và axit amin: Các chất này là tiền chất hoặc đồng yếu tố cho nhiều quá trình trao đổi chất trong cây.
-
Tăng khả năng hấp thụ nước và dinh dưỡng: Nhờ bộ rễ phát triển mạnh mẽ và các cơ chế hỗ trợ hấp thụ.
3.2. Cơ Chế Gián Tiếp (Bảo Vệ/Cải Thiện Môi Trường Rễ)
-
Kiểm soát mầm bệnh (Đối kháng sinh học): Các PGPMs cạnh tranh không gian, dinh dưỡng với vi sinh vật gây hại, hoặc tiết ra chất kháng sinh, enzyme để ức chế chúng. Điều này giúp cây khỏe mạnh hơn, ít bị bệnh.
-
Cải thiện cấu trúc đất: Hoạt động của vi sinh vật giúp kết dính các hạt đất thành cấu trúc viên, làm đất tơi xốp, thoáng khí, tăng khả năng giữ nước và thoát nước, tạo môi trường thuận lợi cho rễ.
-
Giải độc đất: Một số PGPMs có khả năng phân giải các chất độc hại trong đất (như kim loại nặng, dư lượng thuốc bảo vệ thực vật), làm sạch môi trường rễ.
-
Tăng cường sức đề kháng của cây: Kích hoạt hệ thống miễn dịch bẩm sinh của cây trồng, giúp cây chống chịu tốt hơn với các điều kiện stress (hạn hán, mặn, phèn, nhiệt độ cao).
4. Các Yếu Tố Ảnh Hưởng Đến Hoạt Động Của PGPMs
Hoạt động của vi sinh vật kích thích sinh trưởng bị ảnh hưởng bởi nhiều yếu tố môi trường đất:
-
Hàm lượng chất hữu cơ: Là nguồn thức ăn và năng lượng chính cho chúng.
-
Độ pH của đất: Mỗi chủng vi sinh vật có ngưỡng pH hoạt động tối ưu riêng.
-
Độ ẩm và thoáng khí: Cần điều kiện phù hợp (ẩm nhưng không úng, đủ oxy).
-
Nhiệt độ: Ảnh hưởng đến tốc độ trao đổi chất.
-
Sử dụng hóa chất nông nghiệp: Phân hóa học và thuốc trừ sâu là "kẻ thù" của PGPMs, chúng giết chết hoặc ức chế hoạt động của vi sinh vật có lợi.
5. Kỹ Thuật Ứng Dụng Vi Sinh Vật Kích Thích Sinh Trưởng Khoa Học
Để PGPMs phát huy tối đa hiệu quả, cần tuân thủ các nguyên tắc sau:
-
Sử dụng chế phẩm sinh học chất lượng: Mua từ nhà sản xuất uy tín, có nguồn gốc rõ ràng, ghi rõ chủng loại, mật độ vi sinh vật và hạn sử dụng.
-
Cách thức sử dụng:
-
Xử lý hạt giống: Trộn hoặc ngâm hạt giống với chế phẩm trước khi gieo.
-
Nhúng rễ cây con: Trước khi trồng, nhúng rễ cây con vào dung dịch chế phẩm.
-
Bón gốc: Trộn vào đất khi làm đất, bón lót hoặc tưới gốc.
-
Phun qua lá: Pha loãng và phun đều lên cây.
-
Ủ phân hữu cơ: Phối trộn vào đống ủ phân chuồng, phân trộn.
-
-
Thời điểm và tần suất sử dụng: Theo khuyến cáo của nhà sản xuất hoặc chuyên gia nông nghiệp, phù hợp với giai đoạn sinh trưởng của cây.
-
Hạn chế sử dụng hóa chất nông nghiệp: Tránh trộn chung PGPMs với thuốc trừ sâu, thuốc diệt nấm hóa học. Cần cách ly thời gian sử dụng.
-
Kết hợp với chất hữu cơ: PGPMs phát huy hiệu quả tốt nhất khi đất giàu chất hữu cơ.
-
Đảm bảo môi trường đất tối ưu: Điều chỉnh pH, cải thiện cấu trúc, quản lý độ ẩm và thoáng khí.
6. Kết Luận
Vi sinh vật kích thích sinh trưởng là một giải pháp nông nghiệp thông minh, mang lại sức mạnh to lớn từ tự nhiên để thúc đẩy cây phát triển, nâng cao năng suất và chất lượng nông sản. Bằng cách hiểu rõ vai trò của chúng và kiên trì áp dụng kỹ thuật sử dụng PGPMs một cách khoa học, chúng ta có thể giảm thiểu phụ thuộc vào hóa chất nông nghiệp, bảo vệ môi trường và góp phần vào sự phát triển bền vững của nông nghiệp Việt Nam. congnghenongnghiep.vn cam kết cung cấp những kiến thức chuyên sâu để hỗ trợ bà con nông dân trên hành trình này.
Bài viết này được tạo bởi Google Gemini, mặc dù chúng nỗ lực cung cấp thông tin chính xác và cập nhật, Google Gemini là một mô hình AI và có thể mắc sai sót. Do đó, thông tin trong bài viết chỉ mang tính chất tham khảo. Các bạn cần xác minh lại các câu trả lời và tham khảo ý kiến chuyên gia nông nghiệp hoặc các nguồn đáng tin cậy khác trước khi áp dụng bất kỳ kỹ thuật hay biện pháp nào.
Chúng tôi không chịu trách nhiệm cho bất kỳ tổn thất hoặc thiệt hại nào phát sinh từ việc sử dụng thông tin trong bài viết này.
| Bài Trước Đó | Bài Tiếp Theo |